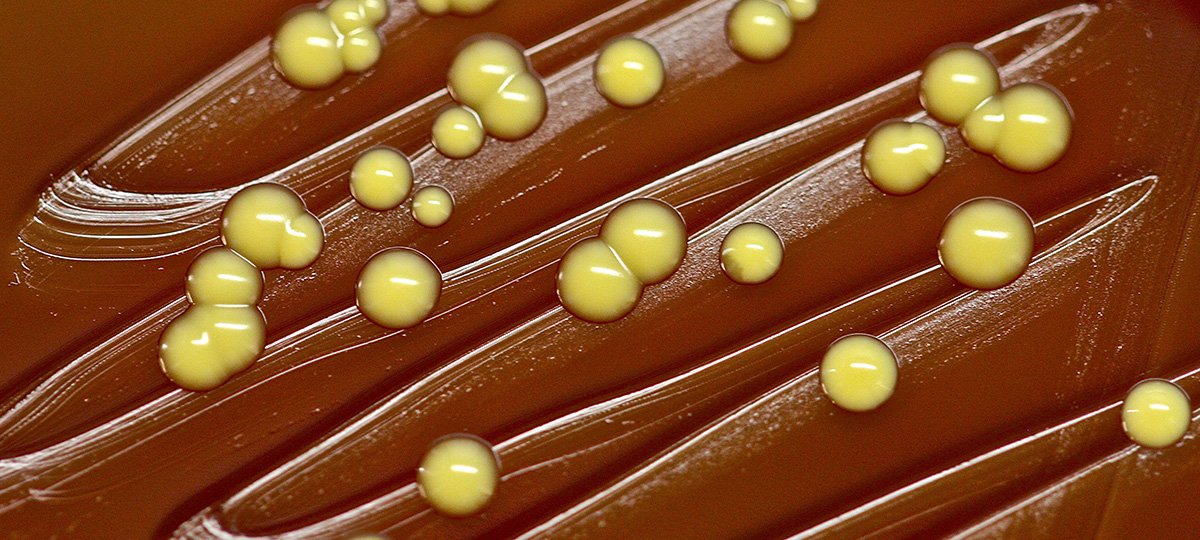
1 2 какие микробы живут на телефоне

какие микробы живут на телефоне
Опасных бактерий в мобильном телефоне в 18 раз больше, чем в туалете

Сегодня многие из нас не выпускают из рук телефоны — ещё в досмартфонную эпоху с их помощью можно было не только связаться с другими людьми, но и выйти в Интернет или воспользоваться медиавозможностями. Современные магазины приложений только добавляют новых функций, благодаря которым телефон становится незаменим для навигации, чатов, игр.
Часто используемые предметы — ключи, монеты, денежные банкноты — собирают грязь при использовании. Не являются исключениями и телефонные трубки. Во множестве случаев накапливаемые микроорганизмы относительно безвредны, они лишь являются следствием плохо вымытых рук или прикосновений к грязным поверхностям. Но бывают и опасные случаи, которые грозят сыпью на коже, заражениями крови и еды.
Британские учёные погрузили корпуса 30 телефонов в чашки Петри, содержавшие благоприятную для роста микроорганизмов среду. На фотографиях представлены результаты трёхдневного роста, а не содержимое мобильников на момент начала эксперимента.
В некоторых случаях встречались экземпляры золотистого стафилококка. Считается, что примерно пятая часть населения является переносчиком этой бактерии, которая сохраняется на коже и в слизистых оболочках верхних дыхательных путей. И эти люди не являются больными.
Но при нарушениях кожного покрова стафилококк может попадать в раны и вызывать инфекционные заболевания. Серьёзность варьируется от угрей, импетиго, фурункулов до пневмонии, менингита, сепсиса, инфекционно-токсического шока. Бактерия легко может распространяться по заражённым поверхностям от человека к человеку.
Другим опасным представителем фауны телефонов является Bacillus mycoides. Обычно эта бактерия обнаруживается в почве, то есть скорее всего аппарат или его пользователь недавно имели контакт с землёй.
Тесты показали, что в среднем мобильный телефон переносит в 18 раз больше бактерий, чем ручка слива в мужском туалете. Почти четверть тестируемых телефонов имела десятикратное превышение уровня заражения. Один экземпляр был настолько грязным, что простой разговор по нему грозил расстройством желудка.
Вы в курсе? На вашем смартфоне может жить даже золотистый стафилококк – объясняем, как избавиться от бактерий на телефоне
Мы мало об этом задумываемся, но на наших смартфонах обитают самые разные микроорганизмы: от бактерий до грибков. Одни из них безобидные, а вот другие могут быть причиной заболеваний и инфекций. Избежать их несложно, если знать, как ухаживать за своим телефоном.
Откуда берутся бактерии на наших смартфонах
Ученые во всем мире уже давно говорят, что наши смартфоны – отличная среда для жизни и размножения бактерий. За последние 10 лет было проведено немало исследований, которые подтверждали это.
Один из последних таких экспериментов провели журналисты Buzzfeed – они собрали пробы с двадцати телефонов сотрудников офиса. Образцы были отправлены в микробиологическую лабораторию, где в течение трех дней микробы росли в чашках Петри. В итоге выяснилось, что абсолютно на всех телефонах, с которых брали пробы, жили бактерии.
При этом, кроме безобидных микроорганизмов, на наших смартфонах обитают и бактерии, которые могут вызвать инфекции кожи и внутренних органов, и патогенные стафилококки: из окружающей среды они попадают на кожу, а потом – на телефон.
А теперь вспомните, сколько раз в день вы касаетесь поручней в транспорте, ручек дверей в магазинах, денег, которые до вас уже держало множество чужих рук. Все собранные микробы легко переносятся на поверхность смартфона. И не забывайте, что телефоном, который – признайтесь – никогда не дезинфицировался, мы касаемся лица, кладем его на подушку, даем поиграть детям.
Какие бактерии обитают на поверхности смартфонов?
Стафилококк эпидермальный – это часть нормальной человеческой флоры: его больше всего на коже и меньше – на слизистой. На телефон он попадает при частом прикосновении к нему или во время разговора.
Микрококки – больше всего этих маленьких бактерий обитает на коже, но они могут быть и в ротовой полости, и дыхательных путях. Поэтому на телефон они тоже попадают во время разговора и при прикосновении к лицу.
Стрептококк вириданс – в основном эти бактерии живут у нас в полости рта на деснах и зубах, а еще в желудочно-кишечном тракте. Так что на смартфон этот стрептококк попадает при разговоре или через пальцы рук – например, если перед этим вы закрывали рот во время кашля или чихания.
Вообще, бактерия считается безвредной для человека, и то, что она является частью нашего организма, – норма. Но при ослаблении иммунитета и попадании ее в кровь есть опасность заболеть пародонтитом, нефритом, фарингитом, скарлатиной, ангиной, отитом, кожными заболеваниями и др.
Моракселла обитает на слизистых оболочках. Эта бактерия является микроорганизмом, чье нахождение в верхних дыхательных путях человека – норма. Но если раньше моракселла считалась безвредной, то сейчас она может привести к менингиту, сепсису, отиту, пневмонии.
Бациллы – их больше всего обитает в окружающей среде, поэтому смартфон может их «подхватить», если, например, положить его на улице на какую-нибудь поверхность.
Но живут на смартфонах и более опасные бактерии
Кроме безобидных бактерий, на телефонах могут обитать и патогенные микроорганизмы, которые отличаются от нормальных микробов и вызывают серьезные заболевания и инфекции. Конечно, их может быть недостаточно для того, чтобы вызвать серьезное заболевание, но знать о них все-таки стоит.
Золотистый стафилококк – бактерия, устойчивая ко многим антибиотикам. Она может жить на коже или в дыхательных путях, в носу – и у многих бактерия не вызывает проблем. К человеку золотистый стафилококк может попасть через поверхности в метро, дверные ручки, общественные душевые и спортивные залы.
При снижении иммунитета, стрессах, расстройствах питания, проникая в организм человека, бактерия может вызывать инфекции: воспаления кожи, пневмонию, сепсис, менингит и другие. А еще ей часто заражаются в медицинских учреждениях – так что там особенно внимательно относитесь к своему смартфону.
Кишечная палочка – существуют различные типы этой бактерии, некоторые из которых совсем безвредные и являются частью нормальной флоры кишечника человека. Но другие могут вызывать серьезные заболевания: палочка попадает в организм при недостаточной гигиене или употреблении плохо приготовленных бургеров, йогурта и сыра из сырого молока, плохо вымытых фруктов и овощей.
Кандида альбиканс – грибок, который присутствует в организме у большинства людей, не вызывая при этом никаких болезней. Только чрезвычайное увеличение его количества или снижение иммунитета вызывает грибковые инфекции. Так что, скорее всего, того количества грибка, которое есть на вашем телефоне, будет недостаточно, чтобы заболеть.
Что делать, чтобы очистить свой смартфон от бактерий?
Вообще, если мыть руки и соблюдать правила гигиены – особенно после посещения уборной, кухни, общественного транспорта, – то можно избежать любого заболевания. Но какой в этом смысл, если мы сразу дотрагиваемся до смартфона – проверить мессенджеры, ответить на письмо, сделать фото?
Чтобы точно обезопасить себя от «плохих» бактерий, нужно как можно чаще чистить поверхность своего телефона и чехол.
Чем протирать?
· Ткань из микрофибры или хотя бы без ворсинок – например, тряпочка для протирания очков. В крайнем случае могут сгодиться антибактериальные салфетки.
· Спрей с разбавленным спиртовым раствором или антибактериальная жидкость для рук.
· Дезинфицирующие очищающие салфетки для гаджетов.
Но ни в коем случае не используйте бытовую химию, включая растворители, чистящие средства для стекол, спирт 90°, – это повредит ваш телефон.
Как протирать?
Перед тем как очистить смартфон от бактерий, отключите его от сети и выключите. Снимите чехол, если он есть, и распылите немного спрея на телефон с расстояния в 20—30 см или увлажните им тряпочку. После этого тщательно протрите гаджет.
Когда будете все это делать, обязательно следите за тем, чтобы жидкость не попала в зарядное гнездо и динамики. И само собой разумеется, что очищать нужно только внешнюю сторону – внутри мыть его не стоит.
Меняйте чехлы
Если на телефоне есть чехол, хотя бы раз в неделю его нужно снимать и протирать ватным диском, смоченным в спиртосодержащем растворе.
Следите за защитной пленкой
Экран телефона часто соприкасается с лицом во время разговоров. По краям защитной пленки скапливается грязь, а в царапинах на пластике застревают бактерии. Поэтому важно регулярно менять пленку на экране.
Не передавайте свой телефон в другие руки
Если вы моете руки после туалета, например, то это не значит, что и все так делают. Поэтому чем меньше ваш телефон будут держать чужие руки, тем меньше и вероятность «забрать» чужие бактерии.
Как часто нужно мыть телефон?
В идеале ежедневно, хотя бы один раз в день. Но, если ходите в уборную вместе со смартфоном, то, кроме мытья рук, не забывайте и телефон помыть.
Бактерии вне зоны доступа: сколько грязи на смартфонах?
Если посмотреть на обычную ленту любой социальной сети с точки зрения микробиологии, картина может показаться пугающей. Люди ведут активную жизнь — фотографируют еду, себя, общественный транспорт, себя в общественном транспорте, себя с едой, животных, природу и детей. Смартфоны сопровождают человека везде, иногда даже в кровати или уборной. Что, гипотетически, с точки зрения микробиологической загрязненности, может поставить гаджеты в один ряд, например, с деньгами. Недавнее исследование британского университета, растиражированное всеми международными СМИ гласило, что на поверхности смартфона содержится огромное количество опасных бактерий — в 18 раз больше, чем на сиденье туалета. Таким образом, предполагается, что мобильные устройства становятся настоящими рассадниками болезнетворных бактерий, среди которых E.Coli (кишечная палочка), золотистый стафилококк, стрептококк, синегнойные палочки, плесень.
Для проведения микробиологической экспертизы «Росконтроль» подобрал 6 флагманских смартфонов разных производителей: Sony Xperia Z3, Apple iPhone 6, LG G3, Samsung Galaxy Note 4, Nokia Lumia 930, HTC One M8.
Безопасная связь
Каждый смартфон перед началом эксплуатации проходил тщательную обработку, всю его поверхность дезинфицировали, после чего он передавался испытателю. Обычный человек поочередно эксплуатировал каждый из образцов в режиме среднестатистического использования. Испытатель передвигался по городу на общественном транспорте и автомобиле, посещал места общепита, магазины, парки, работал в офисе, а на выходных выбирался на природу. При этом, он активно общался по смартфону, в свободное время сидел в соцсетях, играл в игры и, конечно, делал множество фотографий. После каждых 24 часов эксплуатации смартфона (с перерывом на сон) аппарат отправлялся на бактериологическое исследование. На поверхности устройств, в лабораторных условиях искали бактерии группы кишечных палочек, стафилококк золотистый, и прочие патогенные бактерии, в т.ч. сальмонеллы (в ходе исследования ученых из университета Суррея эти бактерии в небольших количествах были обнаружены на смартфонах).
По итогам исследования экспертов было установлено полное отсутствие на поверхности смартфонов патогенных и условно патогенных микроорганизмов. Каждый из образцов, после активной 24-и часовой эксплуатации, с точки зрения микробиологии был полностью безопасен.
Дамир Ярлушкин, эксперт портала «Росконтроль»:
«У почти полного отсутствия микробной обсемененности на поверхности телефонов, установленное в результате проведенного эксперимента могут быть следующие причины:
— для обсеменения любой поверхности необходимо, чтобы туда попали микроорганизмы из окружающей среды, поэтому при соблюдении элементарных правил гигиены это условие можно исключить;
— для выживания и размножения микробам нужна пища, а на поверхности смартфонов отсутствует, либо содержится недостаточно питательной среды для размножения микроорганизмов и сохранения их жизнеспособности;
— микробы чувствительны к температуре окружающей среды: эксплуатация смартфона подразумевает частое изменение температуры окружающей среды, температурный же режим, комфортный для размножения большинства патогенных микроорганизмов подразумевает под собой постоянное сохранение температуры, близкой к температуре тела человека;
— большинство поверхностей смартфонов гладкие. Такие поверхности не располагают к адгезии на них микроорганизмов, а кроме того, при контакте с некоторыми видами поверхностей (одежда, мягкая мебель и пр.) даже предельно малое количество микробов может быть легко удалено.
Если при эксплуатации владелец будет время от времени протирать смартфон салфетками со специальной пропиткой или даже сухой чистой тканью, он практически не оставит шансов для выживания на нем микроорганизмов. Учитывая эти особенности, пользование смартфоном может быть совершенно безопасным с точки зрения микробной обсемененности».
Грани микробиологической безопасности
Одновременно с поиском потенциально опасных бактерий, эксперты проанализировали поверхности смартфона на предмет общей микробной обсемененности. В лабораторных условиях было установлено, какая из представленных моделей «загрязнилась» по итогам эксплуатации больше других.
Самой «чистой» моделью, (с некоторыми оговорками, речь о которых пойдет ниже) можно назвать Nokia Lumia 930 — на ее поверхность из глянцевого пластика бактерии «садились» неохотно. Apple iPhone 6 показал средние результаты, ну а самым «загрязненным» оказался Samsung Galaxy Note 4. Впрочем, стоит отметить, что этот смартфон обладал самой большой площадью поверхности среди всех представленных образцов, что, вероятно, могло поспособствовать более интенсивному распространению бактерий.
Анализ загрязненности всех моделей выделил одну общую для всех смартфонов тенденцию. Больше всего микроорганизмов скапливается не на тыльной или фронтальной стороне устройства, а на «ребрах» аппарата. Разница в количестве бактерий между лицевой частью и боковой поверхностью доходила до 14 раз. Однако, стоит сказать, что полученные данные вовсе не говорят о том, что смартфоны (и их боковые грани) — это «опасные рассадники микробов». Напротив, с точки зрения микробиологии, все показания и разница в полученных результатах (обнаруженных микробов) является практически незаметной. Более того, итог может варьироваться в зависимости от конкретных условий эксплуатации каждого конкретного образца. В целом, полученные показатели количества обнаруженных микроорганизмов говорят о том, что они никак не могут навредить человеку. Например, самый внушительный показатель КМАФАнМ (количество мезофильных аэробных и факультативно-анаэробных микроорганизмов) обнаруженный на «ребрах» модели Samsung Galaxy Note 4 составил 16 КОЕ/см2. В то же время, для детских подгузников, игрушек и изделий медицинского назначения, в соответствии с государственными стандартами, показатель КМАФАнМ не должен превышать 100 КОЕ/см2. Таким образом, «самая грязная» поверхность самого «грязного» смартфона укладывается в строжайший государственный норматив по микробиологической безопасности для детей. Поэтому и «грязным» ни один из представленных смартфонов после среднестатистической эксплуатации назвать нельзя.
Заразительная конструкция
Получив нулевые результаты в поиске потенциально опасных микроорганизмов в ходе ежедневных тестов, эксперты «Росконтроля» провели лабораторное «заражение» или «контомацию» образцов бактериями кишечной палочки. Каждый из смартфонов был тщательно продезинфицирован, после чего на его поверхность был нанесен раствор, содержащий в себе внушительное количество микроорганизмов — были высажены колонии кишечной палочки. После подсыхания смартфонов со всех поверхностей был взяты пробы.
Теоретически, этот эксперимент должен был продемонстрировать, какой из материалов, примененных в смартфоне, является наиболее «притягательным» для условно-опасных микроорганизмов. В итоге прямой зависимости обнаружено не было. На пластиковом покрытии Samsung Galaxy Note 4 и на стеклянных поверхностях Sony Xperia Z3 колонии микробов практически не прижились. Алюминиевый корпус HTC One M8 и глянцевый пластик Nokia Lumia 930 также впечатляющих возможностей по «притягиванию» микробов не продемонстрировали. Зато количество бактерий, выращенных на корпусе Apple iPhone 6 превысило средние показатели теста в 4 раза, а на пластиковом корпусе LG G3 — в 18 раз. Однако и эти значения эксперты относят к разряду «незначительных», аргументируя тем, что даже «повышенное» количество бактерий на LG G3 можно назвать ничтожным. Говорить о потенциальной незащищенности покрытия перед микробами можно было бы тогда, когда количество «смытых» бактерий существенно превысило цифру в 1000 КОЕ/см2
Вызов завершен
Как видно из результатов исследования, утверждение о том, что смартфоны являются «рассадниками бактерий» — ошибочно. Их поверхности, вне зависимости от материала изготовления, являются пространством, на котором микробы размножаются неохотно, а при ежедневном использовании устройств в городских условиях патогенных и условно-патогенных микроорганизмов замечено не было. Так что смартфон, в контексте микробиологии, представляет собой обычный бытовой прибор и «заражение» человека в рамках среднестатистической эксплуатации маловероятно. Общаться в соцсетях, выкладывать фотографии и разговаривать по смартфону можно безопасно, с одной оговоркой, что вы будете соблюдать элементарные правила личной гигиены.
Врач рассказала об опасных микробах на поверхности смартфона
На поверхности телефона может жить огромное количество болезнетворных бактерий, рассказала агентству «Прайм» врач-инфекционист «СМ-Клиника» Наталья Очинская.
По ее словам, в 2015 году в британском Университете Суррея было проведено исследование – ученые брали смывы со смартфонов обычных граждан и установили, что устройства являются настоящим рассадником болезнетворных бактерий.
«В рамках исследования было проверено 30 телефонов обычных людей. Оказалось, что в некоторых случаях на корпусе смартфона может находиться в 18 раз больше бактерий, чем на ободке унитаза и на ручке смыва в мужском туалете», – рассказала Очинская.
По ее словам, на телефоне могут обитать бактерии сальмонеллы, кишечная палочка, стрептококки, золотистый стафилококк и ряд других. Все они способны вызвать серьезные заболевания – от кишечных инфекций и пневмонии, до менингита.
Врач рекомендовала хотя бы раз в день протирать наружные поверхности телефона антибактериальными средствами. При этом устройство нужно отключить от сети, заключила Очинская.
Ранее директор информационно-аналитического агентства Telecom daily Денис Кусков рассказал, что причиной сбоев в работе смартфона в ряде случаев может быть программа-шпион. Наиболее явными признаками вмешательства в работу устройства является внезапно садящаяся батарея, а также перезагрузки в то время, когда аппарат не используется.
Вся правда о микробах на вашем смартфоне и способах борьбы за его чистоту
Подписаться:
Поделиться:
Микробы — это вообще кто? Какими они бывают?
Микроб, он же микроорганизм — это любое существо, которое мы не можем разглядеть невооруженным глазом. То-есть, если вы видите какую-нибудь мелочь без лупы или микроскопа — это просто мелочь, если не видите, а он есть — это микроб. Микробы делятся на множество разновидностей, но вот четыре самые большие группы:
Чем отличаются вредные микробы от полезных?
Микроб микробу рознь, и в гигантском разнообразии жизни эти микроскопические существа выбирают различные стратегии. Большинство из них живут в природных местообитаниях и особо никого не трогают: грызут минералы, перерабатывают мертвую органику и образуют почву, едят то, что произвели другие микробы и вырабатывают то, что съедят следующие. Некоторые из них научились жить там, где не живет никто другой: в почти кипящей воде, во льдах, в околоконцентрированной серной кислоте и так далее.
Некоторые микробы живут на нашей коже и защищают ее от воздействия вредных патогенов, такой же функцией обладает большинство бактерий в кишечнике. Здоровье слизистых человека часто зависит от деятельности этих крохотных помощников, но есть один нюанс: если иммунитет человека начинает его подводить, бывшие помощники могут начать бесконтрольно размножаться и приносить вред своему хозяину. Та же кишечная палочка — дай ей волю или попади она не в правильное место — может причинить много проблем.
Впрочем, у человеческого тела врагов и так предостаточно: это и вирусы, готовые начать кишечную или простудную инфекцию, и бактерии, приводящие к самым разнообразным заболеваниям. Инфекции, вызываемые простейшими и грибами, менее распространены, но про ту же «молочницу» слышали все. Она как раз и является грибковым заболеванием.
Если подытожить, то вред или польза микроба зависят от его изначальной природы, от того, насколько хорошо работает человеческий иммунитет, от того, где этот микроб оказался и насколько ему там хорошо стало жить.
Какие места/вещи являются самыми грязными?
Защититься на 100% от микробов нельзя, но это нам и не требуется. Человеческое тело привыкло взаимодействовать с миллионами крохотных существ: одна только домашняя пыль содержит тысячи видов микробов. К тому же излишняя стерильность может, напротив, навредить иммунитету. Но это не значит, что нужно бросать все на самотек: обратите внимание на самые грязные места в доме, соблюдайте требования гигиены и задумайтесь о своем телефоне.
Какие микробы обитают на телефоне?
Поручни в метро, кнопки лифтов, общественные туалеты — напоминание об этих далеко не самых чистых местах всегда находится у нас под рукой, то есть на нашем смартфоне. Он словно общежитие для микробов, которое ежедневно пополняется новыми студентами. На вашем телефоне могут присутствовать герпесвирусы, герпесвирусы, адено- и риновирусы, ротавирусы и, конечно, коронавирусы. Из опасных бактерий — золотистый стафилококк, стрептококки, кишечная палочка, сальмонелла. Правда, продолжительность их жизни на смартфоне определяется многими условиями. Из грибов — дрожжи рода кандида, а также трихофитоны.
Микробиология пока не позволяет понять, как много бактерий и прочих микробов обитает на смартфоне. Но можно прикинуть это, делая смывы с гаджетов и анализируя всю ДНК, что оказалась в растворе. Каждый раз велик шанс обнаружить нового микроба, до сих пор неизвестного науке. Но и без «новичков» опасностей предостаточно: вы можете хранить на экране возбудителей респираторных кишечных инфекций, а также заболеваний кожи.
Как избежать неприятных последствий от использования телефона?
Не забывать, что гаджет в руке — это не только устройство для получения информации, но и гладкая поверхность, к которой вы прикасаетесь сотни раз в день. А учитывая тот факт, что около 40 раз в час вы касаетесь и собственного лица, то микроскопические жители смартфона рано или поздно оказываются и нем. Пандемия напомнила нам о необходимости мыть руки, но все еще не выработала привычку следить за своими гаджетами. Если у вас есть желание позаботиться о здоровье, можно сделать следующее:
Как часто нужно обрабатывать смартфон?
Это зависит от того, как смартфоном пользоваться. Если не мыть руки, пользоваться телефоном в общественном транспорте, давать его другим людям – конечно обработка должна происходить чаще. Но самый простой способ: «вспомнили – протерли». Главное – всегда иметь удобное средство под рукой.
Как работают популярные дезинфицирующие вещества?
Итак, наш мир кишит всевозможными микроорганизмами: кто-то приносит пользу, кто-то — вред, кому то до вас нет никакого дела. Бояться микробов не стоит, нужно просто знать, где их искать и как с ними обращаться.